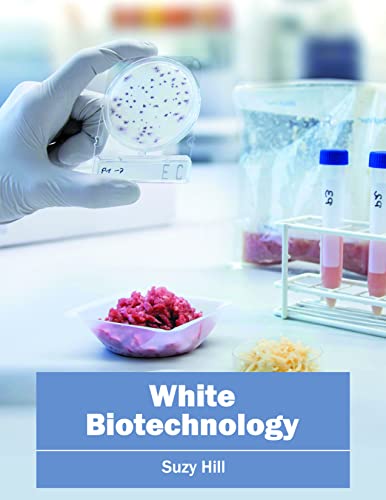
White Biotechnology

No description available....

No description available....

No description available....

No description available....

No description available....

No description available....

No description available....

No description available....